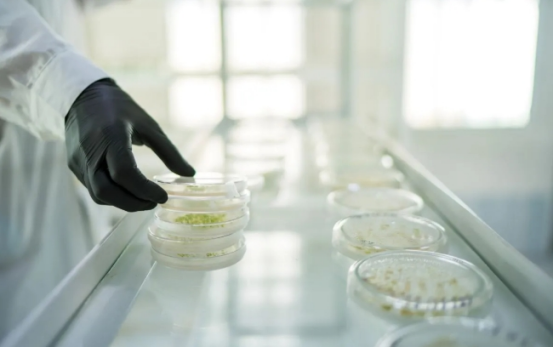

Изменения в правилах аудита иностранных лабораторий для проведения испытаний семян сельскохозяйственных растений Россеменнадзором вступят в силу 1 сентября 2025 года. Согласно материалам Россеменнадзора сельскохозяйственных растений, теперь проверки могут проводиться без согласования компетентных органов иностранных государств.
"В частности, отменяется обязанность согласовывать с уполномоченными органами зарубежных государств проверку их лабораторий должностными лицами Российской службы по контролю семян сельскохозяйственных растений с целью подтверждения возможностей, методов и результатов исследований",-сообщает ведомство.
Новым основанием для проведения аудита является документация любой формы – заявление о проведении аудита, а также информация об устранении нарушений, выявленных в ходе предыдущей аудиторской деятельности. Иностранная лаборатория или уполномоченный орган страны направляет документы в российскую службу, а уведомление о проверке направляется иностранной лаборатории.
Эти реформы также повлияли на нормативные требования федерального правительства по обеспечению качества и безопасности зерновых и продуктов, переработанных из зерна. Положение дополняется нормой, согласно которой Россельхознадзор (Россельхознадзор) осуществляет федеральное регулирование зерна при его выращивании. Ранее в России таких четких положений не существовало.
Также внесены изменения в перечень сведений, подлежащих включению в Федеральную географическую информационную систему (ФГИС) "Зерно" при формировании и ведении реестра юридических лиц и предпринимателей, осуществляющих деятельность по хранению зерна и оказанию складских услуг. Перечень оказываемых услуг дополнен услугами по переработке зерна.









